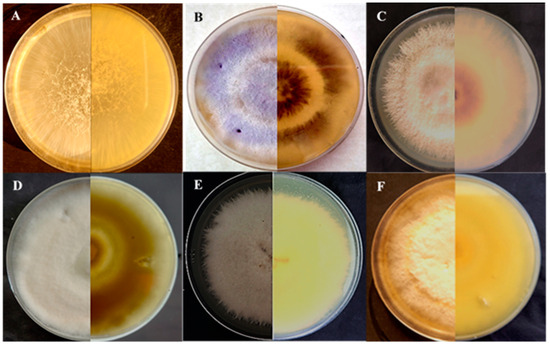
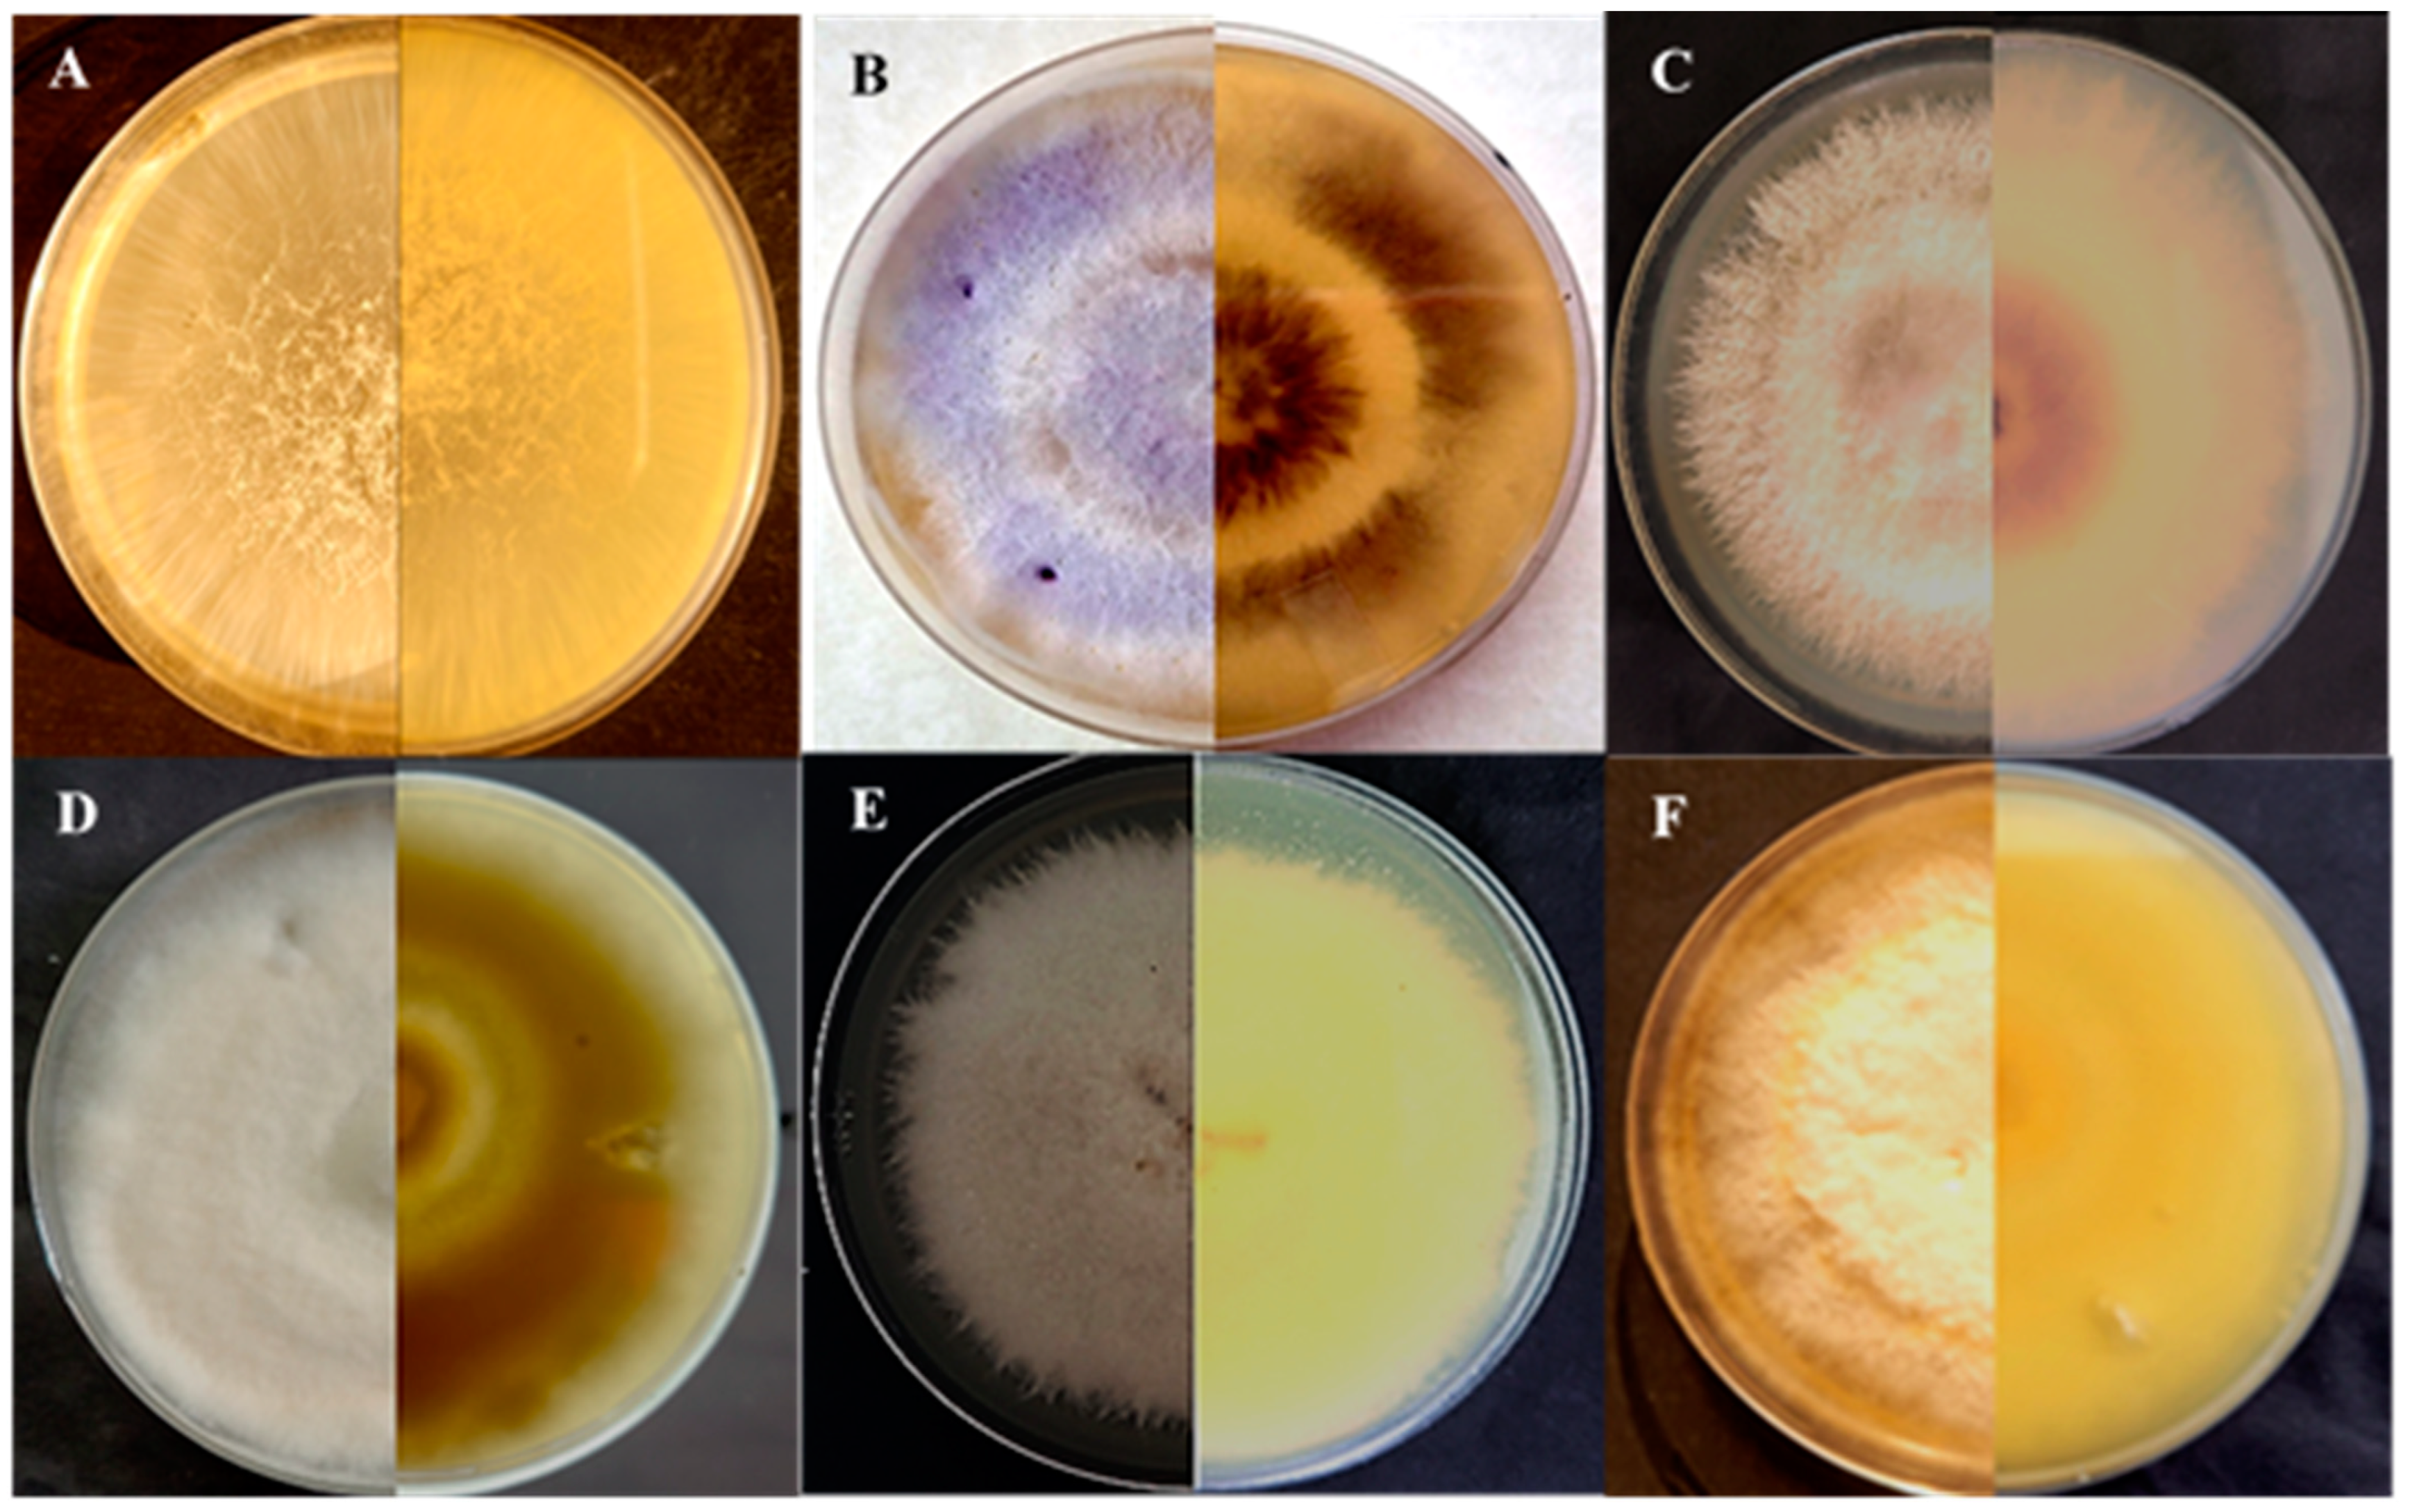
Jof 10 00701 g001
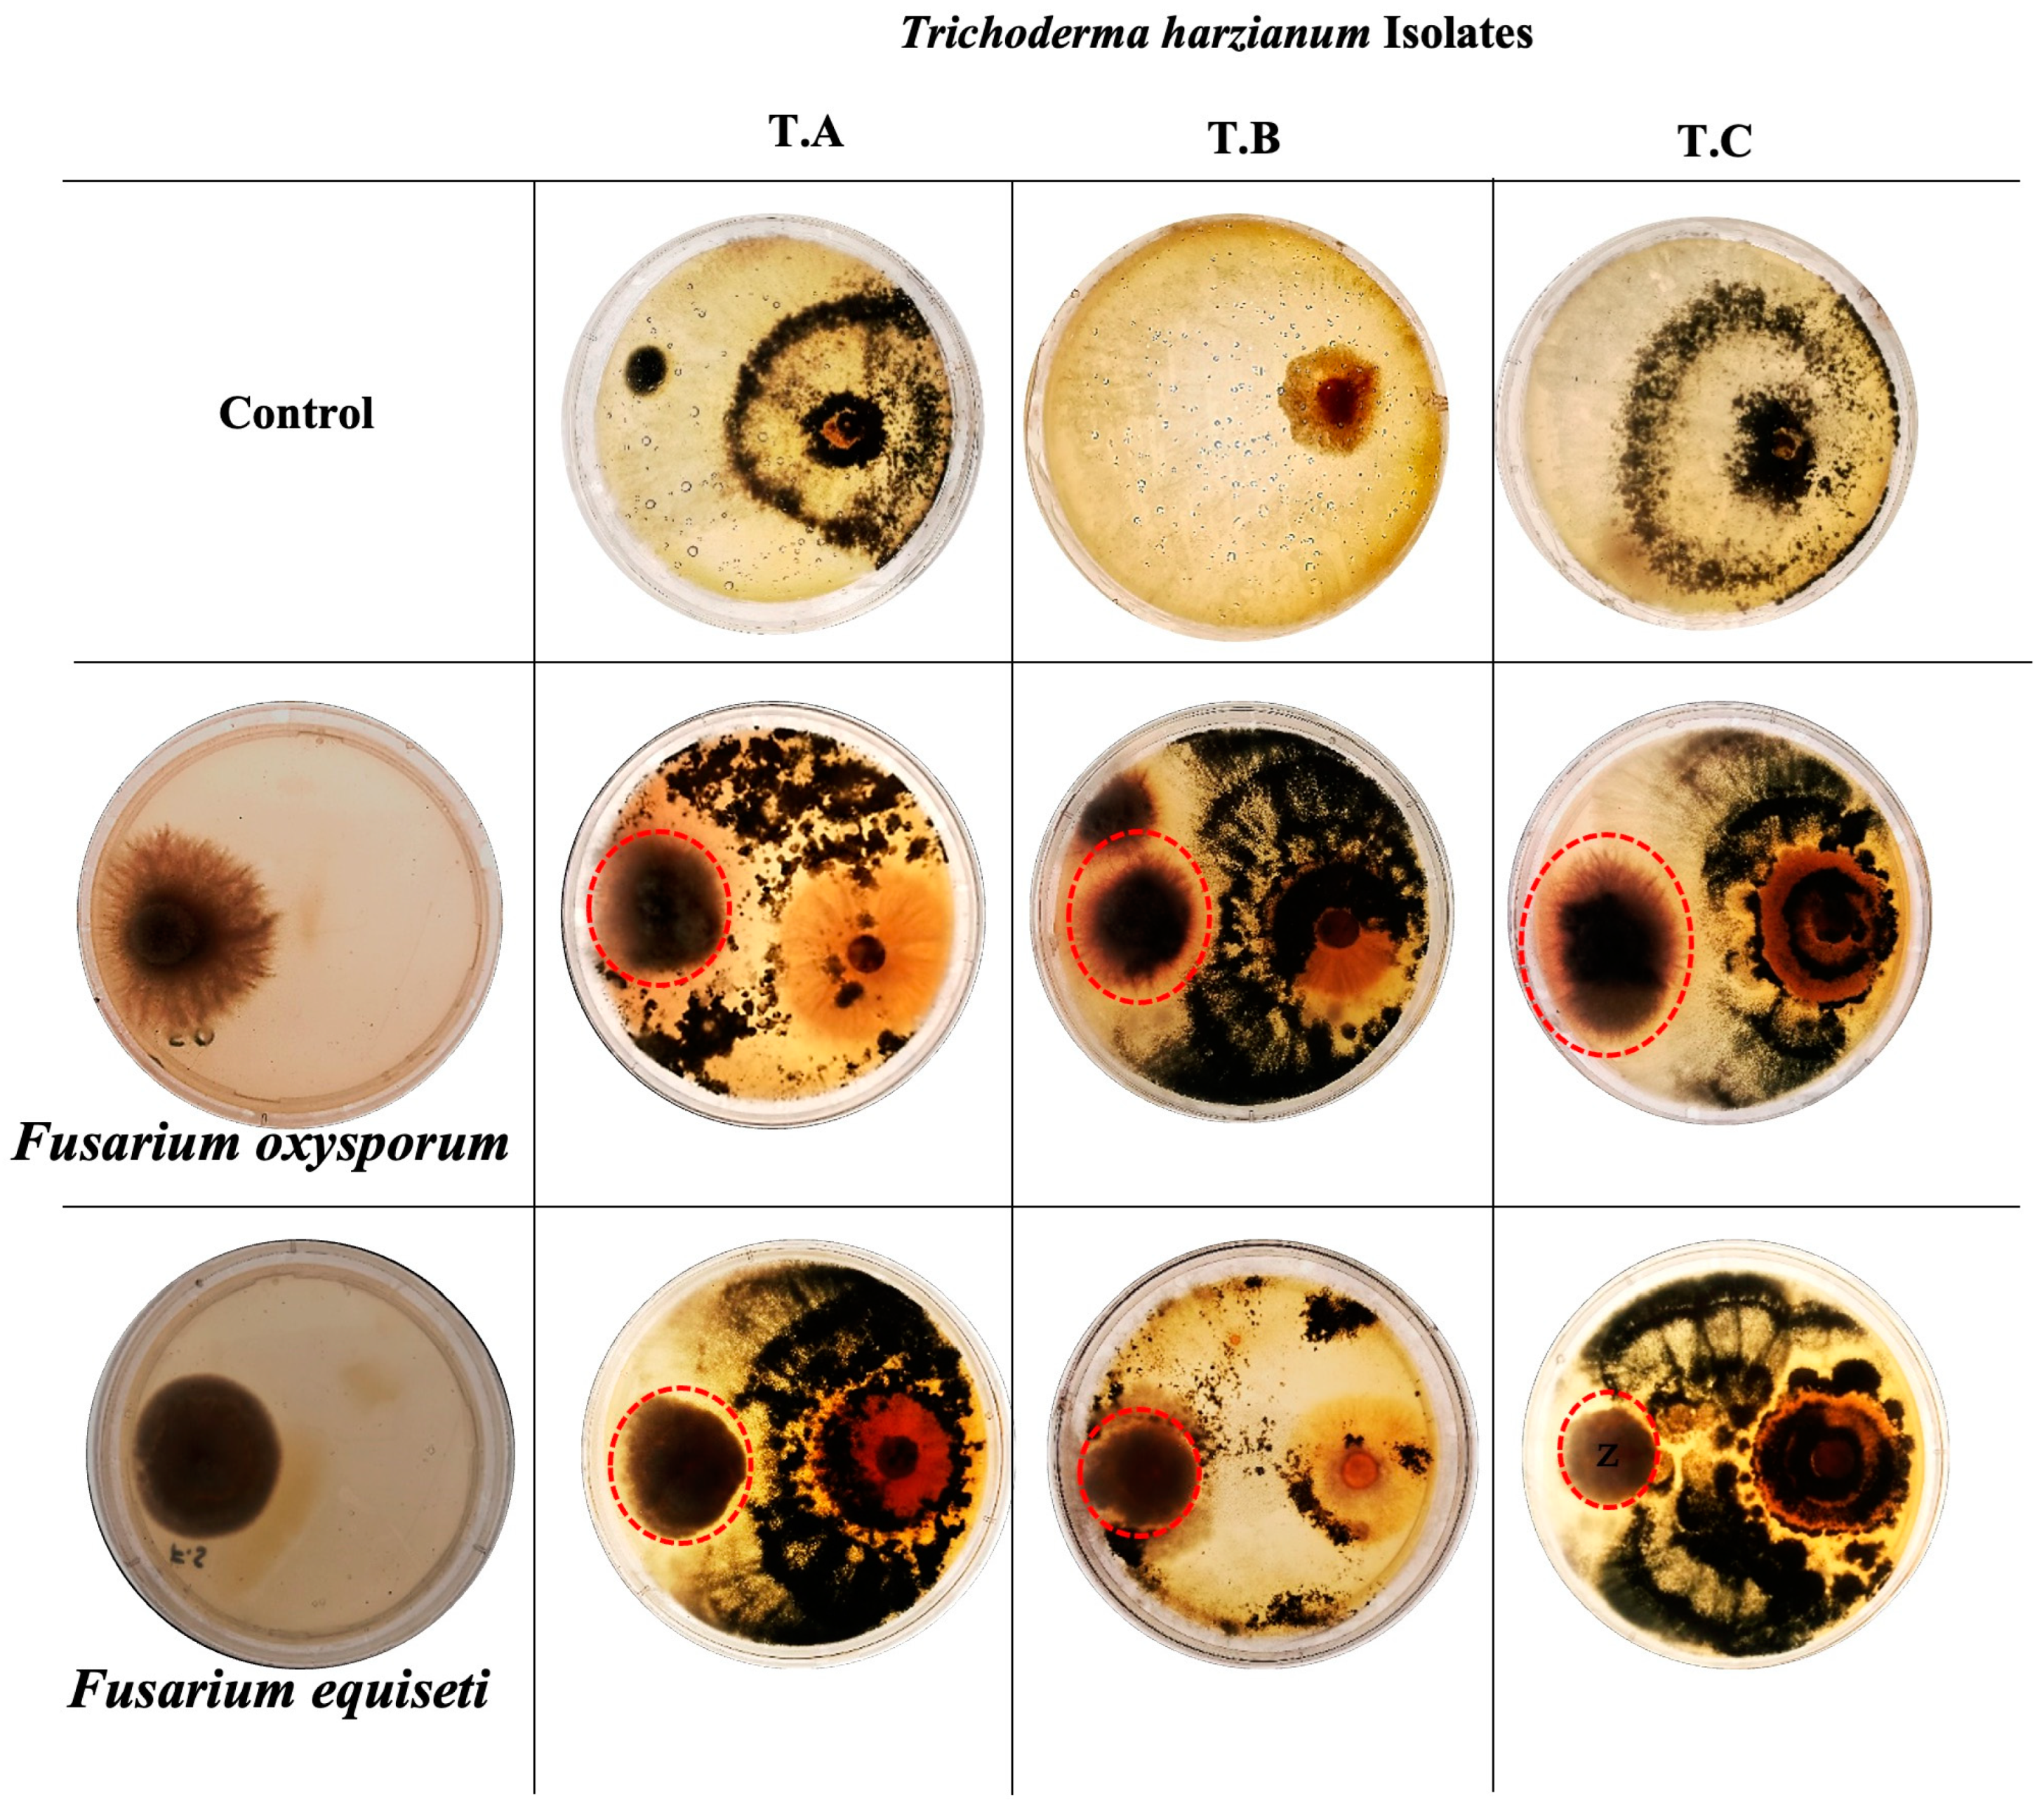
Jof 10 00701 g007

Abstract
Potato (Solanum tuberosum L.) is one of the emerging staple crops in Pakistan, with Punjab producing over 95% of the country’s potatoes. Wilt is an emerging threat to the potato crop worldwide, including in Pakistan. We identified and characterized Fusarium species associated with potato wilt in Pakistan through morphological and molecular analyses. Samples were collected during the 2020–2022 potato seasons from five major potato-growing regions: Sahiwal, Chichawatni, Pakpattan, Kamalia, and Faisalabad. Morphological characterization, internal transcribed spacer (ITS) sequencing, specific translation elongation factor 1-alpha (TEF) sequencing, and phylogenetic analysis were used to identify six different Fusarium species: F. oxysporum, F. equiseti, F. incarnatum, F. fujikuroi, F. annulatum and F. thapsinum. Pathogenicity tests in a greenhouse revealed that F. oxysporum and F. equiseti were responsible for Fusarium wilt in all sampled regions, with F. oxysporum being more prevalent in wilted samples. This is the first report of F. equiseti on wilted potatoes in Pakistan. In vitro biocontrol tests using Trichoderma harzianum showed 89% inhibition against F. equiseti and 65% inhibition against F. oxysporum. These findings on F. equiseti will aid in developing future control strategies, including biocontrol measures for Fusarium wilt in potatoes.
1. Introduction
Potato (Solanum tuberosum L.) is the third most economically important staple crop worldwide, after rice and wheat [1]. In Pakistan, three potato crops are produced annually in the spring, summer, and autumn, depending on the temperature of that region. Potatoes are grown in different ecological conditions in Pakistan, from hilly to plain areas [2]. Pakistan is the ninth largest producer of potatoes worldwide, with 7.94 million tons of production, according to official data for 2022–2023 [3]. Potato tubers are a rich source of water, carbohydrates, vitamins, mineral elements, proteins, and fats and play an essential role in the food security of developing countries, which produce more than half of the total world production [4,5]. The crop is popular due to its nutritional quality and easy availability in Pakistan and elsewhere [5,6].
Potato production needs to meet demand in Pakistan and falls behind neighboring Bangladesh and India [7]. Lower production is due to several abiotic and biotic stresses and relatively limited land available for potato cultivation. Biotic constraints drastically impact the growth and production of potatoes and include low-yielding varieties and diseases caused by viral infections, bacterial wilt, oomycete, fungal pathogens, and nematode parasites [8]. These constraints are prevalent in Pakistan and cause seasonal fluctuations in potato production [9].
Fungal pathogens cause considerable losses in potato production from field to storage [10]. The genus Fusarium is one of the most essential mycotoxigenic fungal genera of phytopathogenic fungi, which causes wilting of stems and leaves in the field and tuber dry rot during storage [11]. Fusarium wilt is a vascular disease caused by several Fusarium species [12,13].
Species of Fusarium are filamentous, hyaline fungi most commonly found in soil, water, plants, and organic substrates [13,14]. Taxonomic classification of Fusarium species is an ongoing and dynamic process (www.fusarium.org, accessed on 7 September 2024). Approximately two hundred Fusarium species have been identified [15]. Fusarium spp. infect plants through roots and then colonize xylem vessels of the stem [16]. Fusarium pathogens survive in plant parts and can remain viable in soils for many years. Fusarium wilt symptoms include yellowing of leaves (chlorosis), necrosis primarily on leaf margins that curl slightly, stunting of growth, and wilting of leaves. Stems usually remain a dark, dull green after leaves wilt. Vascular tissue of stems, roots, and leaf petioles turn brown with some brownish flecking of the pith [17,18].
Fusarium equiseti is a Fusarium species associated with chili wilt [19]. It is reported as a weak pathogen affecting cereals and is rarely found to be related to Fusarium head blight-diseased kernels [20]. This species is commonly found in tropical and sub-tropical areas [21]. However, the pathogenicity of this species has been underestimated. The species belongs to the F. incarnatum–F. equiseti complex and is genetically diverse [19]. They are economically important species, as they caused severe vascular wilts and root rot diseases in various crops, including potatoes [22]. The F. oxysporum isolates are very diverse and exhibit considerable variation in their cultural, morphological, and pathogenic characteristics. In culture, F. oxysporum produces colorless to pale yellow mycelia that turn pink or purple with age. Potato plants infected by F. oxysporum exhibit yellowing, wilting, and drying that eventually lead to the death of the leaves. The wilting of plants may be caused by toxins produced by the fungus [23,24,25,26,27,28,29]. The F. oxysporum spores germinate to form mycelia, which enter the roots and find their way to xylem vessels [26]. Ultimately, the plant will wilt and die. Infected plant parts remain in the soil and can serve as a source of inoculum for future crops [24]. Disease prevalence of Fusarium wilt (Fusarium oxysporum f.sp. lycopersici) in tomatoes was determined in the primary tomato-growing regions within Punjab, Pakistan [30]. The 92 isolates of Fusarium oxysporum were morphologically identified from chili pepper in Punjab, Pakistan [31].
Integrated disease management practices are traditionally applied to tackle these biological stress factors influencing potato production [32]. They include using disease-free seeds or resistant varieties, environmental monitoring, and chemical pesticide applications [33]. Conventional control measures include certified pathogen-free seeds and long crop rotation [34]. Using resistant varieties is the most appropriate method to control soil-borne diseases [32]. In the absence of resistant varieties, chemical control is an alternative to combat disease. Bio fungicides and biocontrol agents such as Trichoderma species can also effectively manage Fusarium wilt [13].
This study aims to address the significant threat posed by Fusarium wilt to potato crops in Pakistan by identifying the specific Fusarium species responsible for the disease. By utilizing sequencing of PCR-amplified internal transcribed spacer (ITS) regions and specific translation elongation factor 1-alpha (TEF) regions, we seek to accurately determine the Fusarium species associated with potato wilt. Additionally, we will evaluate the pathogenicity of the primary culprits, F. oxysporum and F. equiseti, to understand their impact on potato plants. Furthermore, we will explore the potential of Trichoderma harzianum as a biocontrol agent against these pathogens in vitro. This comprehensive approach will contribute to the development of effective control strategies and enhance the management of Fusarium wilt in potato crops in Pakistan.
2. Materials and Methods
2.1. Sampling, Isolation, and Morphological Characterisation of Fungal Cultures
Symptomatic leaves showing browning and necrotic spots were collected from Kamalia (30°46′00.3″ N 72°36′48.1″ E), Chichawatni, (30°35′45.2″ N 72°48′29.6″ E; 30°46′00.3″ N 72°48′29.6″ E), Sahiwal (30°42′51.3″ N 73°04′48.5″ E; 30°42′51.6″ N 73°04′48.4″ E; 30°45′58.6″ N 73°00′44.5″ E; 30°45′58.9″ N 73°00′44.7″ E), Pakpattan (30°25′14.8″ N 73°31′40.8″ E), and Faisalabad (31°23′36.71″ N 73°2′6.14″ E) in polythene bags from mid-season (February) to the harvesting season (April) in 2021 and 2022. All the samples were brought to the Gene Transformation lab at the National Institute for Biotechnology and Genetic Engineering (NIBGE) and stored at 4 °C before processing. The infected potato leaves were washed with tap water to remove soil particles. Infected leaves were then surface sterilized with 1% mercuric chloride (Millipore Sigma, Burlington, VT, USA) for 3 min, followed by three consecutive washes in distilled water. Leaves were cut into small pieces containing the necrotic lesion and living tissue. Four leaf pieces were placed on Petri plates containing potato dextrose agar (PDA) (Merck KGaA, Darmstadt, Germany) amended with ampicillin (20 mg/mL) and rifampicin (75 mg/mL; Thermo Fisher Scientific, Waltham, MA, USA). All the plates were sealed with parafilm tape (Pechiney, Paris, France), labeled with an isolate code and date of isolation, and incubated at 25 °C with 12 h of light per day for 4–7 days.
2.2. Morphological Identification
Different fungal colonies were observed on the PDA medium, but only typical colonies with Fusarium features were selected. Each isolate was purified using a hyphal tip and single-spore technique [35]. Morphological characteristics (e.g., spore shape, mycelium septation, colony form, colony color, colony diameter) of isolates were examined using a binocular compound microscope (Bausch & Lomb, Laval, Canada). The diameter of the colony was measured in mm after seven days (Table 1) The morphological features were confirmed by comparing them with the published literature [22,36].
2.3. DNA Extraction for Molecular Characterization
After 7–10 days of incubation, mycelia from the media were scraped with a sterile scalpel and ground into a fine powder in liquid nitrogen using a mortar and pestle. The genomic DNA of Fusarium isolates was extracted using the cetyl trimethyl ammonium bromide (CTAB) method [37]. The crushed sample was placed into a 1.5 mL centrifuge tube containing 700 µL of CTAB buffer. Samples were incubated in a water bath (Polysciences, Warrington, PA, USA) at 65 °C while mixing every 10 min. After 30 min, samples were cooled to room temperature, and 700 µL of 24:1 chloroform/isoamyl alcohol (Research Organics, Cleveland, OH, USA) and 2.5 µL of RNAse (Thermo Fisher Scientific, Waltham, MA, USA) were added. Samples were mixed by inverting and shaking, followed by centrifugation (Hermle Benchmark, Franklin, TN, USA) for 15 min at 13,000 rpm. The upper layer was transferred into a new autoclaved 1.5 mL centrifuge tube containing 500 µL of isopropanol (Millipore Sigma, Burlington, VT, USA) and 1/10 vol 3 M sodium acetate (Thermo Fisher Scientific, Waltham, MA, USA). The solution was mixed and stored at −20 °C for 30 min. Samples were centrifuged for 15 min at 13,000 rpm to pellet the DNA. The supernatant was discarded, and the pellet was washed with 200 µL of 70% ethanol (Millipore Sigma, Burlington, VT, USA), followed by centrifugation for 2 min at 13,000 rpm. DNA pellets were dried at 37 °C for 15 min and dissolved in 70 µL of sterilized distilled water.
2.4. PCR Amplification and Sequencing
PCR amplification of the internal transcribed spacer (ITS) region was carried out using primer set ITS1, 5′-TCCGTAGGTGAACCTGCGG-3′, and ITS-4, 5′-TCCTCCCGCTTATTG ATATGC-3′ [38], and for translation elongation factor 1-alpha (TEF) using primer set TEF F 5′-ATGGGTAAGGAGGACAAGAC-3′ and TEF R 5′ ACGGGTTAGCATGAGAAGGT-3′ [39,40]. A 25 µL mixture was used for amplification, and each mixture contained 15 µL of Dream Taq DNA polymerase (Thermo Fisher Scientific, USA), 9 µL of sterile distilled water, 2 µL of 50 ng/µL genomic DNA, and 1 µL each of 10 µM reverse and forward primers. The PCR mixture was incubated in a thermal cycler (Bio-Rad, Hercules, CA, USA) and programmed with an initial denaturation at 95 °C for 5 min, followed by 35 cycles of amplification consisting of denaturation at 95 °C for 30 s, an annealing temp of 55 °C for 30 s and extension at 72 °C for 45 s, followed by a final extension at 72 °C for 10 min. The amplified product (2 µL) was loaded on 1% agarose gel with ethidium bromide and observed using a UV gel documentation system (Bio-Rad, Hercules, CA, USA). The amplified PCR products were cleaned using a Monarch PCR DNA Cleanup kit (New England Biolabs, Ipswich, MA, USA) and cloned into PTZ using a Fermantas Insta TA clone PCR cloning kit according to the manufacturer’s instructions. The presence of the inserts was confirmed by Sma1 and Xba1 (Thermo Fisher Scientific, Waltham, MA, USA) restriction enzyme digestion and by PCR amplification using M13 F 5′-GTAAAACGACGGCCAGT and M13 R 5′-CAGGAAACAGCTATGAC primers. The purified PCR product was sequenced using the Sanger sequencing method (Functional Biosciences, Madison, WI, USA). The same primers used for PCR amplification were also used for sequencing.
2.5. Sequence Analysis and Alignment
The sequences were assembled using BioEdit software version 7.7.1 to produce complete contigs from forward and reverse sequences. Basic local alignment search tool (BLAST v. 11.0.13) analysis was performed to check the sequence similarities of sequenced isolates with already-deposited sequences (reference sequences) in the National Center for Biotechnology Information (NCBI). The species names were assigned to the isolates after comparison with the representative sequences available in NCBI. The isolate sequences were submitted to GenBank, and accession numbers are listed in Table 2. The sequences were aligned using Clustal W in MEGA11 version 11-0-13 [41].
2.6. Phylogenetic Analysis
To resolve the relationship among Fusarium isolates, a phylogenetic tree was created by using the Maximum Likelihood method and Jukes–Cantor model for ITS, TEF-1α [41,42]. The percentage of trees in which the associated taxa clustered together in the bootstrap test (1000 replicates) is shown next to the branches. Initial tree(s) for the heuristic search were obtained automatically by applying Neighbor-Join and BioNJ algorithms to a matrix of pairwise distances estimated using the Jukes–Cantor model, and then selecting the topology with superior log likelihood value. All positions containing gaps and missing data were eliminated (complete deletion option). Evolutionary analyses were conducted in MEGA11 [41]. Reference sequences used in analysis are according to [43].
2.7. Pathogenicity Assay to Confirm the Virulence of F. oxysporum and F. equiseti
Fusarium oxysporum and F. equiseti inocula were grown in potato dextrose broth (Sigma-Aldrich). After five days of incubation at 25 °C in a shaker incubator, the purity of the culture was checked by microscopic visualization. The culture was filtered through cheese cloth and centrifuged for 2 min at 12,000 rpm at room temperature. The pellet was dissolved in 10 mL of autoclaved water, and spores were counted using a hemocytometer. A total volume of 5 mL of inoculum was applied to the potato variety Kuroda. Fungal inoculum was applied following Ford (2003) with a modification that involved using 220-grit silicon carbide paper (3M Science. Applied to Life, Maplewood, NJ, USA). In total, 5 ml of inoculum was applied to silicon carbide paper and gently pressed against the abaxial surface of leaflets near the middle of the plant. Three leaflets per plant were inoculated for this purpose. Plants were kept in a glass house at 25–27 °C and 16/8 h light/dark in pots with three replicates. Plants were visually analyzed and rated as resistant, moderately resistant, susceptible, and severely susceptible by observing the symptom severity visually seven days following inoculation. An ordinal rating scale of 0–4 was used, where 0 = healthy plant leaves (resistant), 1 = yellowing of plant leaves (moderately resistant), 3 = browning/wilting of plants (susceptible), and 4 = blackening/death of plants (severely susceptible). Symptomatic leaves were collected for re-isolation, and isolates were confirmed by sequencing the ITS region as described previously. A pathogenicity test for wilt was conducted for all the isolates of the study in replication. Symptoms of yellowing and wilting of leaves on each stem were noted for all the inoculated replicates and control plants. The disease index was calculated using the formula:
where severity of symptoms was rated by the following criteria: no symptoms, healthy plants = 0; yellowing on 25% of plant = 1; yellowing and blackening on 25–50% of plant = 2; yellowing and blackening on 50–75% of plant = 3; blackening on 75–100% of plant (plant death) = 4
2.8. Effect of F. equiseti and F. oxysporum on Tuber Production
F. equiseti and F. oxysporum were used to inoculate Kuroda, AGB red, AGB pink, and AGB CH2 to determine the effect on tuber production. Plants were grown in a greenhouse with a controlled temperature of 25–27 °C and a 16/8 h light/dark period in pots with three replicates. Plants were inoculated with pathogens using silicon carbide paper as described previously. Plants were observed visually as the symptoms appeared. Tubers of each potato genotype were also grown in replicates in a field in October 2023 at NIBGE, Faisalabad. Plants were grown in 6 rows per plot with 6 plants in each row. Two rows were used as a non-inoculated control for AGB red and Kuroda. Two rows were used to inoculate AGB red and Kuroda with F. oxysporum, and two rows were used to inoculate the two host genotypes with F. equiseti. Plants were inoculated using an abrasive sheet as described previously. Plants were inoculated after 4 weeks of cultivation. Potato tubers were harvested in February 2024. Plant tuber data were collected, including the number of potatoes per plant and their average mass.
2.9. In Vitro Antagonistic Activity of Trichoderma Harzianum
For the in vitro evaluation of the antagonistic potential of Trichoderma harzanium, strains named T.A, T.B, and T.C, obtained from the Gene Transformation lab (NIBGE), were tested against F. oxysporum and F. equiseti using a dual-culture technique [44]. Fungal pathogens were separately grown on PDA for 5–7 days at 25 ± 2 °C. Likewise, T. harzianum was grown on PDA plates at 25 ± 2 °C for five days. Mycelial disks (8 mm diameter) of pathogens and antagonistic strains were inoculated onto fresh PDA plates, such that the pathogen was at one edge and the antagonist on the other side of the plate, both at a 1.5 cm distance from their respective edges. Control plates had only fungal pathogens at one edge of the plate. Both control and test plates were incubated at 25 ± 2 °C for seven days. The diameter of radial growth of the fungal pathogens grown without and with antagonist fungus was determined, and the percentage growth inhibition was calculated as %growth inhibition = (A − B)/A × 100, where A represents the growth of the fungal pathogen in the control plate in cm, and B refers to the fungal growth in the test plate in cm [45].
3. Results
3.1. Morphological Characterization of Isolates
Ninety pure culture colonies with the apparent characteristics of Fusarium were isolated from all the samples. The surface characteristics, reverse color, colony color, and diameter of the fungal isolates are shown in Table 1 and ratings were determined based on previously published studies [22,36]. Surface and reverse characteristics are shown in Figure 1. Based on this morphological characterization, we determined that fungal isolates from this study consist of six different species: F. equiseti, F. oxysporum, F. incarnatum, F. annulatum, F. fujikuroi and F. thapsinum. F. oxysporum and F. equiseti were the predominant species in all the diseased samples.
Figure 1.
Front and back images of Fusarium cultures. (A) F. fujikuroi; (B) F. annulatum; (C) F. oxysporum; (D) F. equiseti; (E) F. thapsinum; and (F) F. incarnatum. Images were taken after 14 days of growth.

Table 1.
Morphological characteristics of different Fusarium species.
Fusarium isolates categorized in the F. fujikuroi species complex (FFSC) produced moderately slender macroconidia with little curvature and did not produce chlamydospores. F. fujikuroi is placed in this category, producing club-shaped or copious ovate microconidia in shorter chains from monophialides and monophilalides with flattened bases comprising zero to one septum [46]. The F. incarnatum and F. equiseti species complex (FIESC) includes Fusarium isolates producing macroconidia with a crescent form or dorsiventral curvature. F. incarnatum placed in FIESC consisted of macroconidia with three to seven septa, slightly curved or straight, and fusiform with conical basal cells and a pointed apex [47,48]. Microscopic analyses of F. equiseti showed smooth branched and cylindrical hyphae, oval microconidia consisting of 0-1 septa, and curved and tapered macroconidia with 2-5 septa and elongated apical cells (Figure 2). Fusarium placed in the F. oxysporum species complex (FOSC) produced curved macroconidia, fusiform, with pointed, tapering, sometimes hooked apical cells and distinctly pedicellate basal cells consisting of three to five septa. Chlamydospores were also formed. F. oxysporum had branched, cylindrical, and smooth hyphae with ellipsoidal to cylindrical, straight, or curved microconidia bearing 0-1 septa. Macrocondia were pointed at both ends, consisting of 2-4 septa (Figure 2). Fusarium oxysporum and F. equiseti isolates were more prevalent among all the isolates from different locations taken from diseased leaves. Therefore, these two species were used for further experiments.

Figure 2.
Representative photos of Fusarium mycelia and spores were taken using a binocular compound microscope (Bausch & Lomb Galen). (A) Macroconidia spores of F. equiseti; (B) mycelia of F. equiseti; (C) macroconidia spores of F. equiseti; (D) macroconidia spores of F. oxysporum; (E) macroconidia spores of F. oxysporum; (F) macroconidia spores of F. incarnatum. Scale bars: (A,B) = 100 µm; (C–E) = 25 µm; (F) = 10 µm.
3.2. Molecular Characterization of Isolates
We confirmed morphologically identified isolates using ITS region sequence analysis. ITS sequences were compared to already published sequences of reference species. All the sequences showed 95–100% sequence identity with previously published sequences present within the NCBI GenBank database. ITS sequences from this work were used to assign species names according to references, submitted to NCBI GenBank, and accession numbers were obtained (Table 2). Our results indicated the presence of six species collected from different regions of Pakistan, including F. thapsinum, F. annulatum, F. fujikuroi, F. incarnatum, F. oxysporum and F. equiseti.

Table 2.
Fusarium isolates used in this study and ITS sequence information.
3.3. Evolutionary Analysis by Maximum Likelihood Method for ITS and TEF 1α Sequences
The evolutionary history was inferred using the Maximum Likelihood method and Jukes–Cantor model. The tree with the highest log likelihood (-2013.04) is shown (Figure 3). The percentage of trees in which the associated taxa clustered together is shown next to the branches. Initial tree(s) for the heuristic search were obtained automatically by applying Neighbor-Join and BioNJ algorithms to a matrix of pairwise distances estimated using the Jukes–Cantor model, and then selecting the topology with a superior log likelihood value. Fusarium stilboides was used as an outgroup for the TEF-1α gene phylogenetic tree. Fusarium lateritium was used as an outgroup for ITS sequence phylogenetic tree analysis and subsequent identification. Isolates from this study are marked red and type material from Genbank is marked green.


Figure 3.
(a) Phylogenetic tree of partial TEF gene sequences for the evolutionary relationship of isolates by Maximum Likelihood method. Sequences shown in red are isolates from this study. TEF sequence from Fusarium stilboides was used as an outgroup. (b) Phylogenetic tree of partial ITS gene sequences for the evolutionary relationship of isolates by Maximum Likelihood method. Sequences shown in red are isolates from this study. GenBank accession numbers of ITS sequences are followed by the species name from which the sequences originated. ITS sequence from Fusarium lateritium was used as an outgroup. For both trees, red circles indicate isolation from Pakistan and green circles are database-derived sequences.
A phylogenetic tree of seven ITS sequences showed that isolates grouped with their respective Fusarium reference sequences (Figure 3). Isolates were also distributed in clades based on related species and showed evolutionary relationships among different species of Fusarium. The sequences of Fusarium isolates formed the same cluster with F. equiseti and F. oxysporum but in separate sub-clusters. There was a total of 460 positions in the final dataset. The results showed that isolates AB 9 and AB 25 nested with F. oxysporum, while isolates AB 10 and AB 13 nested with F. equiseti. Isolate AB 12 nested with F. thapsinum, isolate AB 26 with F. annulatum, isolate AB 27 with F. fujikuroi, and isolate AB 39 with F. incarnatum.
3.4. Fusarium Pathogenicity Test
The pathogenicity of isolated fungi was confirmed using Koch’s postulates with greenhouse-grown Kuroda plants. Disease symptoms developed 7–14 days following inoculation and were visualized as light green to yellowish discoloration of leaves and necrosis (Figure 4), followed by wilting to death of the whole plant. When the collar region of the plant was cut vertically, the vascular bundles showed brownish discoloration. The potato plants were observed daily to follow disease progress. The most rapid development of symptoms started on day 7, caused by F. oxysporum isolates AB 9 and AB 25, followed by F. equiseti isolates AB 10 and AB 13, which induced symptoms 14 days after inoculation. Non-inoculated and water-inoculated control plants did not develop any symptoms. Plants inoculated with isolates of species F. thapsinum, F. annulatum, F. fujikuroi, and F. incarnatum did not show any wilting symptoms. The disease index was calculated using symptom scores 15 days post inoculation. Isolates of F. oxysporum showed wilting and yellowing of leaves with a disease index of 30 and 33.33 for isolates AB 9 and AB 25, respectively. F. equiseti isolates AB 10 and AB 13 developed symptoms on leaves to a lesser degree with disease indexes of 27.7 and 25, respectively. However, the complete foliage of the inoculated plants with both F. oxysporum and F. equiseti withered and all plants inoculated with these isolates were dead at the end of the trial. The pathogens were re-isolated from infected leaves and resembled the original culture in morphology.

Figure 4.
Symptoms of development of F. oxysporum on potato leaves. Photos were taken of greenhouse-grown plants 7 days after inoculation with F. oxysporum.
Additional potato genotypes were tested with pathogenic Fusarium isolates, and based on physical observations, it was noted that AGB red and AGB CH2 exhibited only moderate symptoms compared to AGB pink and Kuroda, each of which had severe symptoms that led to plant death (Table 3). On this basis, AGB red and AGB CH2 were rated as resistant varieties compared to AGB pink and Kuroda.

Table 3.
Tuber production of greenhouse-grown plants inoculated with Fusarium.
Potato cultivars AGB red and Kuroda were selected based on their resistance and susceptibility, respectively, against F. equiseti and F. oxysporum. Compared to control plants, plants treated with F. equiseti and F. oxysporum showed a reduction in tuber production, and their average mass was less than that of control plants. Among both Fusarium species, F. oxysporum resulted in lower tuber mass than F. equiseti (Figure 5).

Figure 5.
Series one represents the AGB red variety and series 2 represents the Kuroda variety. Solid bars in both series represent the control plants; the striped bar represents the average tuber mass in grams of plants treated with Fusarium equiseti; and the dotted bar represents the average tuber mass of plants treated with Fusarium oxysporum.
3.5. Antagonistic Effect of Trichoderma on Fusarium Strains
To test the impact of the biocontrol fungus Trichoderma harzianum on the growth of collected Fusarium isolates, we grew both T. harzianum and Fusarium on plates and monitored their growth (dual-culture assay). We found that T. harzianum inhibited the growth of both F. oxysporum and F. equiseti, but to different degrees (Figure 6, Table 4). In the dual-culture assay, T. harzianum showed faster growth than pathogenic fungi. After two days of incubation, T. harzianum began restricting the growth of the pathogen as determined by visual observation (Figure 7). At five days, T. harzianum occupied most of the growth media. In the case of F. oxysporum, T. harzianum showed maximum inhibition of 65.21% and for F. equiseti, T. harzianum inhibited growth by 89.12%.

Figure 6.
Tubers from greenhouse-grown plants inoculated with Fusarium oxysporum. (A) Kuroda; (B) AGB pink; (C) AGB red; (D) AGB CH2.

Table 4.
Inhibition of pathogen growth by antagonistic Trichoderma harzianum.

Figure 7.
Inhibitory effect of Trichoderma harzianum on Fusarium growth (red circles). The upper row shows control for T. harzianum T.A, T.B and T.C and the left column shows control of Fusarium oxysporum and equiseti. The second row shows Trichoderma harzianum with F. oxysporum, while the lower panel shows T. harzianum with F. equiseti. Control shows the development of fungal pathogens in the absence of T. harzianum and vice versa.
4. Discussion
Fusarium, a fungal species belonging to Ascomycota, is a prominent genus of over 1500 species. Several strains are reported for their pathogenicity to animals or plants [49]. Fusarium wilt is a soil-borne infection that ideally grows and infects plants at 34 °C or below 17 °C. Fusarium wilts reduce the yields of various economically important crops, such as fruits, cereals, and vegetables. Symptoms appear as marginal yellowing, sometimes chlorosis of adult plants, root rot, and damping off in young seedlings [50]. The pathogen causing wilting in potatoes collected throughout the major potato-growing region of Pakistan was isolated, characterized, and later confirmed as F. oxysporum and F. equiseti based on morphological descriptions and ITS and TEF sequencing. Six species of Fusarium were identified among isolates in this study. Fusarium oxysporum and F. equiseti were predominant in all the wilted potato leaf samples. According to previous studies, F. oxysporum and F. equiseti are the most common species isolated from potato wilt-diseased samples. Our results are in line with previous work that identified F. oxysporum as the dominant species with 50% isolation frequency, followed by F. equiseti at 20%, F. redolens at 20% and F. acuminatum with 10% isolation frequency [12]. However, we did not find F. redolent and F. acuminatum in our study. Instead, we found other Fusarium species including F. incarnatum, F. fujikuroi, F. thapsinum, and F. annulatum.
The present study evaluated F. oxysporum and F. equiseti isolates for their pathogenicity on multiple potato genotypes. We identified the role of F. equiseti for the first time in Pakistan along with F. oxysporum in the wilting of potatoes through re-isolation and pathogenicity assays following Koch’s postulates. Initial symptoms were first recorded for F. oxysporum, indicating it is more virulent than F. equiseti. Fusarium oxysporum was reported to cause wilting and devastating damage in Hidaka, Kochi, Japan, in 2008 [51]. Mousa et al. [52] reported Fusarium oxysporum as a causal agent for Fusarium wilt in sweet potato genotypes, and Cui et al. [53] reported Fusarium equiseti as a causal agent of wilting in potatoes in Zhengyi City, China. In Pakistan, most Fusarium equiseti species causing wilting in tomatoes have been reported from the northern area of Pakistan, Khyber-Pakhtunkhwa [54]. If we compare all the studies of wilt, F. oxysporum is the pathogen that is identified the most. However, we have determined that F. equiseti can also cause wilt in potatoes and can be found in high frequency in potato fields in Pakistan.
In addition to the clear identification of two wilt pathogens via Koch’s postulates, other Fusarium isolates were identified along with diseased samples. In the present study, ITS sequencing identified different isolates of Fusarium, including F. incarnatum, F. thapsinum, F. fujikuroi, and F. annulatum, along with F. oxysporum and F. equiseti.
Sequencing data showed different isolates of Fusarium, but not all of the Fusarium species were found to be pathogenic on potatoes. Our pathogenicity assay showed that F. oxysporum was more virulent than F. equiseti. The virulence assay on potato genotypes revealed that Kuroda was more susceptible than AGB pink, AGB CH2, and AGB red. AGB red was the most resistant among these four genotypes. Evaluation of tuber production revealed that F. oxysporum caused more reduction in mass, leading to an overall decrease in yield compared to F. equiseti.
During the last 3 to 4 decades, research has been reported on establishing biocontrol of Fusarium plant diseases [49]. Species of Trichoderma have been reported to be able to be used as a biocontrol agent against Fusarium wilt of many field crops, including potato, the efficiency of which may vary due to different agricultural and climatical conditions [55,56]. Laboratory and greenhouse experiments are vital for initial evaluation as preliminary tests [57]. In the work presented here, Trichoderma harzianum was evaluated for its antagonistic effect against F. oxysporum and F. equiseti. The results showed that T. harzianum can be a biocontrol agent against F. oxysporum and F. equiseti. The repressing effect of Trichoderma harzianum against F. oxysporum and F. equiseti may be due to antibiosis or competition.
5. Conclusions
This study is the first report of F. equiseti causing potato wilting in Punjab, Pakistan. Based on the phenotypical observation of plants during 2021 and 2022 in mostly potato-growing regions in the Punjab province of Pakistan, symptoms of Fusarium wilt were commonly found in the field compared to other fungal pathogens. Excessive use of appropriate fungicides might also be the reason for the excessive prevalence of disease incidence. Different isolates of Fusarium were identified through sequencing of the ITS and TEF regions; their pathogenicity was confirmed, and their effect on tuber production was evaluated. Among all the Fusarium species, our findings depict that F. oxysporum and F. equiseti are most common and that F. oxysporum is more virulent. Research on emerging diseases of crops has been carried out or is currently being performed in the developed world. However, there are relatively few research contributions from developing countries like Pakistan, where a changing climate is having the most dramatic effect. Exploring the emergence of new pathogens and pathogen genotypes in developing countries is essential so that scientists can track changes over time and provide recommendations for disease control appropriately.
Author Contributions
Conceptualization, A.B., N.A.S. and D.H.; methodology, A.B., M.H., A.I. and A.R.; software, M.A.B.W. and Z.A.; validation, D.H., F.M. and Z.A.; formal analysis, I.U. and A.B.; investigation, A.B. and D.H.; resources, N.A.S. and F.M.; data curation, M.A.B.W.; writing—original draft preparation, A.B.; writing—review and editing, D.H. and I.U.; visualization, A.B. and N.A.S.; supervision, N.A.S. and D.H.; project administration, N.A.S., F.M. and D.H.; funding acquisition, D.H. All authors have read and agreed to the published version of the manuscript.
Funding
This research received no external funding.
Institutional Review Board Statement
Not applicable.
Informed Consent Statement
Not applicable.
Data Availability Statement
The isolates are available.
Conflicts of Interest
The authors declare no conflicts of interest. The findings and conclusions in this publication are those of the author(s) and should not be construed to represent any official USDA or United States Government determination or policy.
References
- Nasir, M.W.; Toth, Z. Effect of drought stress on potato production: A review. Agronomy 2022, 12, 635. [Google Scholar] [CrossRef]
- Khan, N.P.; Akhtar, J. Competitiveness and policy analysis of potato production in different agro-ecological zones of Northern Areas: Implications for food security and poverty alleviation. Pak. Dev. Rev. 2006, 45, 1137–1154. [Google Scholar]
- Hassan, S.I.; Khan, A.; Iqbal, R.A.; Khan, R.A.; Sajid, M.N.; Javaid, T.; Hussain, M.M. Evolution of an indigenously developed climate-resilient potato variety “Kashmir” in Punjab, Pakistan. Int. J. Agric. Ext. 2024, 12, 173–181. [Google Scholar]
- Kumari, M.; Kumar, M.; Solankey, S.S. Breeding Potato for Quality Improvement; Intech Open: London, UK, 2018; Volume 10. [Google Scholar]
- Wijesinha-Bettoni, R.; Mouillé, B. The contribution of potatoes to global food security, nutrition and healthy diets. Am. J. Potato Res. 2019, 96, 139–149. [Google Scholar] [CrossRef]
- Devaux, A.; Kromann, P.; Ortiz, O. Potatoes for sustainable global food security. Potato Res. 2014, 57, 185–199. [Google Scholar] [CrossRef]
- Bashir, M.K.; Ali, A.; Farrukh, M.U.; Alam, M. Estimation of economic and production efficiency of potato production in central Punjab, Pakistan. Custos E Agronegocio Line 2021, 17, 2–23. [Google Scholar]
- Majeed, A.; Muhammad, Z. Potato production in Pakistan: Challenges and prospective management strategies—A review. Pak. J. Bot 2018, 50, 2077–2084. [Google Scholar]
- Zaheer, K.; Akhtar, M.H. Potato production, usage, and nutrition—A review. Crit. Rev. Food Sci. Nutr. 2016, 56, 711–721. [Google Scholar] [CrossRef]
- Adolf, B.; Andrade-Piedra, J.; Bittara Molina, F.; Przetakiewicz, J.; Hausladen, H.; Kromann, P.; Lees, A.; Lindqvist-Kreuze, H.; Perez, W.; Secor, G.A. Fungal, oomycete, and plasmodiophorid diseases of potato. In The Potato Crop: Its Agricultural, Nutritional and Social Contribution to Humankind; Springer International Publishing: Cham, Switzerland, 2020; pp. 307–350. [Google Scholar]
- Akosah, Y.A.; Kostennikova, Z.S.; Lutfullin, M.T.; Lutfullina, G.F.; Afordoanyi, D.M.; Vologin, S.G.; Mardanova, A.M. Induced expression of CYP51a and HK1 genes associated with penconazole and fludioxonil resistance in the potato pathogen Fusarium oxysporum. Microorganisms 2023, 11, 1257. [Google Scholar] [CrossRef]
- Jia, R.; Kang, L.; Addrah, M.E.; Zhang, J.; Xu, L.; Zhang, Z.; Chen, W.; Liu, J.; Zhao, J. Potato wilt caused by co-infection of Fusarium spp. and Verticillium dahliae in potato plants. Eur. J. Plant Pathol. 2023, 165, 305–315. [Google Scholar] [CrossRef]
- Okungbowa, F.; Shittu, H. Fusarium wilts: An overview. Environ. Res. J 2012, 6, 83–102. [Google Scholar]
- Radulesco, T.; Varoquaux, A.; Ranque, S.; Dessi, P.; Michel, J.; Cassagne, C. Maxillary fungus balls due to Fusarium proliferatum. J. Mycol. Méd. 2019, 29, 59–61. [Google Scholar] [CrossRef]
- Caliskan, Z.C.; Karahan, G.; Koray, N.; Gokcinar, Y.; Gülmez, D.; Arikan-Akdagli, S.; Unal, S.; Uzun, O. Invasive fungal rhinosinusitis by Fusarium proliferatum/annulatum in a patient with acute myeloid leukemia: A case report and review of the literature. J. Med. Mycol. 2024, 34, 101461. [Google Scholar] [CrossRef] [PubMed]
- Dewan, M.M.; AL-Asadi, A.H.; AL-Abedy, A.N. New report of the pathogenic isolate of Fusarium solani isolated from Iraqi Potato tubers infected with Fusarium dry rot. Ecol. Environ. Conserv. 2020, 26, 78–82. [Google Scholar]
- Azil, N.; Stefańczyk, E.; Sobkowiak, S.; Chihat, S.; Boureghda, H.; Śliwka, J. Identification and pathogenicity of Fusarium spp. associated with tuber dry rot and wilt of potato in Algeria. Eur. J. Plant Pathol. 2021, 159, 495–509. [Google Scholar] [CrossRef]
- Singh, C.; Vyas, D. The trends in the evaluation of fusarium wilt of chickpea. In Diagnostics of Plant Diseases; Intech Open: London, UK, 2021. [Google Scholar]
- Hami, A.; Rasool, R.S.; Khan, N.A.; Mansoor, S.; Mir, M.A.; Ahmed, N.; Masoodi, K.Z. Morpho-molecular identification and first report of Fusarium equiseti in causing chilli wilt from Kashmir (Northern Himalayas). Sci. Rep. 2021, 11, 3610. [Google Scholar]
- Goswami, R.S.; Kistler, H.C. Heading for disaster: Fusarium graminearum on cereal crops. Mol. Plant Pathol. 2004, 5, 515–525. [Google Scholar] [CrossRef]
- Goswami, R.S.; Dong, Y.; Punja, Z.K. Host range and mycotoxin production by Fusarium equiseti isolates originating from ginseng fields1. Can. J. Plant Pathol. 2008, 30, 155–160. [Google Scholar] [CrossRef]
- Nelson, P.E.; Horst, R.K.; Woltz, S.S. Fusarium Diseases of Ornamental Plants. In Fusarium: Diseases, Biology and Taxonomy; Nelson, P.E., Toussoun, T.A., Cook, R.J., Eds.; The Pennsylvania State University Press, University Park: Philadelphia, PA, USA; London, UK, 1981; pp. 121–128. [Google Scholar]
- Armstrong, G.; Armstrong, J.; Nelson, P.; Toussoun, T.; Cook, R. Fusarium: Diseases, biology and taxonomy. In Formae Speciales and Races of Fusarium Oxysporum Causing Wilt Diseases; Pennsylvania State University Press, University Park: Philadelphia, PA, USA, 1981; pp. 391–399. [Google Scholar]
- Gordon, T.R. Fusarium oxysporum and the Fusarium wilt syndrome. Annu. Rev. Phytopathol. 2017, 55, 23–39. [Google Scholar] [CrossRef]
- Begum, H.A.; Ahmad, W.; Rafiq, N.; Ali, H.; Hussain, S.; Ali, B.; Ullah, I.; Baloch, I.A.; Khan, A. Exploring the pharmacological potential of Trametes hirsuta (White Rot Fungi): Analgesic, anti-Inflammatory, antispasmodic and antimicrobial activities. Pure Appl. Biol. 2023, 12, 1183–1193. [Google Scholar] [CrossRef]
- Ghosal, D.; Datta, B. Molecular characterization of Secreted in Xylem 1 (Six1) gene of Fusarium oxysporum causing wilt of potato (Solanum tuberosum). Plant Pathol. 2024, 73, 1847–1858. [Google Scholar] [CrossRef]
- Gavrilova, O.; Orina, A.; Trubin, I.; Gagkaeva, T. Identification and Pathogenicity of Fusarium Fungi Associated with Dry Rot of Potato Tubers. Microorganisms 2024, 12, 598. [Google Scholar] [CrossRef]
- Bayona, L.G.; Grajales, A.; Cárdenas, M.E.; Sierra, R.; Lozano, G.; Garavito, M.F.; de García, M.C.C.; Bernal, A.; Jiménez, P.; Restrepo, S. Isolation and characterization of two strains of Fusarium oxysporum causing potato dry rot in Solanum tuberosum in Colombia. Rev. Iberoam. Micol. 2011, 28, 166–172. [Google Scholar] [CrossRef]
- Akosah, Y.A.; Vologin, S.G.; Lutfullin, M.T.; Hadieva, G.F.; Scyganova, N.F.; Zamalieva, F.F.; Mardanova, A.M. Fusarium oxysporum strains from wilting potato plants: Potential causal agents of dry rot disease in potato tubers. Res. Crops 2021, 22, 49–53. [Google Scholar]
- Ahmad, S.; Yousaf, M.; Anjum, R.; Raza, W.; Rehman, M.A.; Ali, Y. Prevalence of Fusarium wilt of tomato in major tomato growing areas of Punjab, Pakistan. Int. J. Phytopathol. 2021, 10, 225–230. [Google Scholar] [CrossRef]
- Zeeshan, M.; Mukhtar, T.; Inam-ul-Haq, M.; Asad, M.J. Incidence, characterization and pathogenic variability of Fusarium oxysporum in the Punjab province of Pakistan. Int. J. Phytopathol. 2023, 12, 19–29. [Google Scholar] [CrossRef]
- Fiers, M.; Edel-Hermann, V.; Chatot, C.; Le Hingrat, Y.; Alabouvette, C.; Steinberg, C. Potato soil-borne diseases. A review. Agron. Sustain. Dev. 2012, 32, 93–132. [Google Scholar] [CrossRef]
- Gupta, A.; Kumar, R. Management of seed-borne diseases: An integrated approach. In Seed-Borne Diseases of Agricultural Crops: Detection, Diagnosis & Management; Springer: Berlin/Heidelberg, Germany, 2020; pp. 717–745. [Google Scholar]
- Munyaneza, J.E.; Bizimungu, B. Management of potato pests and diseases in Africa. In Insect Pests of Potato; Elsevier: Amsterdam, The Netherlands, 2022; pp. 407–426. [Google Scholar]
- Pathak, V.N. Essentials of Plant Pathology; CABI Digital Library: Oxfordshire, UK, 1972. [Google Scholar]
- Leslie, J.F.; Summerell, B.A. The Fusarium Laboratory Manual; John Wiley & Sons: Hoboken, NJ, USA, 2008. [Google Scholar]
- Stewart, C., Jr.; Via, L.E. A rapid CTAB DNA isolation technique useful for RAPD fingerprinting and other PCR applications. 1993, 14, 748–50.
- White, T.J.; Bruns, T.; Lee, S.; Taylor, J. Amplification and direct sequencing of fungal ribosomal RNA genes for phylogenetics. PCR Protoc. A Guide Methods Appl. 1990, 18, 315–322. [Google Scholar]
- Fuyao, S.; Tangwei, Z.; Yujun, X.; Chengcheng, D.; Deji, C.; Xiaojun, Y.; Xuelian, W.; Mduduzi, P.M.; Ademola, O.O.; Jianrong, S. Characterization of Fusarium species causing head blight of highland barley (qingke) in Tibet, China. Int. J. Food Microbiol. 2024, 418, 110728. [Google Scholar] [CrossRef]
- O’Donnell, K.; Kistler, H.C.; Cigelnik, E.; Ploetz, R.C. Multiple evolutionary origins of the fungus causing Panama disease of banana: Concordant evidence from nuclear and mitochondrial gene genealogies. Proc. Natl. Acad. Sci. USA 1998, 95, 2044–2049. [Google Scholar] [CrossRef]
- Tamura, K.; Stecher, G.; Kumar, S. MEGA11: Molecular evolutionary genetics analysis version 11. Mol. Biol. Evol. 2021, 38, 3022–3027. [Google Scholar] [CrossRef] [PubMed]
- Jukes, T.H.; Cantor, C.R. Evolution of protein molecules. Mamm. Protein Metab. 1969, 3, 21–132. [Google Scholar]
- Crous, P.; Sandoval-Denis, M.; Costa, M.; Groenewald, J.; Van Iperen, A.; Starink-Willemse, M.; Hernández-Restrepo, M.; Kandemir, H.; Ulaszewski, B.; De Boer, W. Fusarium and allied fusarioid taxa (FUSA). 1. Fungal Syst. Evol. 2022, 9, 161–200. [Google Scholar] [CrossRef]
- Liu, R.; Chen, M.; Gao, J.; Luo, M.; Wang, G. Identification of antagonistic fungi and their antifungal activities against aconite root rot pathogens. Plant Signal. Behav. 2023, 18, 2211852. [Google Scholar] [CrossRef]
- Awad, N.E.; Kassem, H.A.; Hamed, M.A.; El-Feky, A.M.; Elnaggar, M.A.; Mahmoud, K.; Ali, M.A. Isolation and characterization of the bioactive metabolites from the soil derived fungus Trichoderma viride. Mycology 2018, 9, 70–80. [Google Scholar] [CrossRef] [PubMed]
- Jiang, H.; Wu, N.; Jin, S.; Ahmed, T.; Wang, H.; Li, B.; Wu, X.; Bao, Y.; Liu, F.; Zhang, J.-Z. Identification of rice seed-derived Fusarium spp. and development of LAMP assay against Fusarium fujikuroi. Pathogens 2020, 10, 1. [Google Scholar] [CrossRef]
- Avila, C.F.; Moreira, G.M.; Nicolli, C.P.; Gomes, L.B.; Abreu, L.M.; Pfenning, L.H.; Haidukowski, M.; Moretti, A.; Logrieco, A.; Del Ponte, E.M. Fusarium incarnatum-equiseti species complex associated with Brazilian rice: Phylogeny, morphology and toxigenic potential. Int. J. Food Microbiol. 2019, 306, 108267. [Google Scholar] [CrossRef]
- Zemankoa, M.; Lebeda, A. Fusarium species, their taxonomy, variability and significance. Plant Prot. Sci. 2001, 37, 25–42. [Google Scholar] [CrossRef]
- Arie, T. Fusarium diseases of cultivated plants, control, diagnosis, and molecular and genetic studies. J. Pestic. Sci. 2019, 44, 275–281. [Google Scholar] [CrossRef]
- Zitter, T.A. Fusarium wilt of melon, a worldwide problem in temperate and tropical regions. In Proceedings of the I International Symposium on Cucurbits, Adana, Turkey, 20–23 May 1997; pp. 157–162. [Google Scholar]
- Inami, K.; Yoshioka, C.; Hirano, Y.; Kawabe, M.; Tsushima, S.; Teraoka, T.; Arie, T. Real-time PCR for differential determination of the tomato wilt fungus, Fusarium oxysporum f. sp. lycopersici, and its races. J. Gen. Plant Pathol. 2010, 76, 116–121. [Google Scholar] [CrossRef]
- Mousa, T.; Farag, F.; Armanious, H.; Salem, A.; Galal, A. Fusarium Wilt of Sweet Potato Caused by Fusarium oxysporum f. sp. batatas in Egypt. Egypt. J. Phytopathol. 2018, 46, 21–35. [Google Scholar] [CrossRef]
- Cui, L.; Yang, C.; Yang, L.; Jin, M.; Wei, L. First report of fusarium equiseti causing fusarium wilt on potato (Solanum tuberosum) in China. Plant Dis. 2021, 105, 2013. [Google Scholar] [CrossRef] [PubMed]
- Akbar, A.; Hussain, S.; Ullah, K.; Fahim, M.; Ali, G.S. Detection, virulence and genetic diversity of Fusarium species infecting tomato in Northern Pakistan. PLoS ONE 2018, 13, e0203613. [Google Scholar] [CrossRef] [PubMed]
- Sharon, E.; Bar-Eyal, M.; Chet, I.; Herrera-Estrella, A.; Kleifeld, O.; Spiegel, Y. Biological control of the root-knot nematode Meloidogyne javanica by Trichoderma harzianum. Phytopathology 2001, 91, 687–693. [Google Scholar] [CrossRef]
- Wells, H.D.; Bell, D.K.; Jaworski, C.A. Efficacy of Trichoderma Harzianum as a Biocontrol for Sclerotium Rolfsii; CABI Digital Library: Oxfordshire, UK, 1972. [Google Scholar]
- Ommati, F.; Zaker, M.; Mohammadi, A. Biological control of Fusarium wilt of potato (Fusarium oxysporum f. sp. tuberosi) by Trichoderma isolates under field condition and their effect on yield. J. Crop Prot. 2013, 2, 435–442. [Google Scholar]
Disclaimer/Publisher’s Note: The statements, opinions and data contained in all publications are solely those of the individual author(s) and contributor(s) and not of MDPI and/or the editor(s). MDPI and/or the editor(s) disclaim responsibility for any injury to people or property resulting from any ideas, methods, instructions or products referred to in the content. |
© 2024 by the authors. Licensee MDPI, Basel, Switzerland. This article is an open access article distributed under the terms and conditions of the Creative Commons Attribution (CC BY) license (https://creativecommons.org/licenses/by/4.0/).